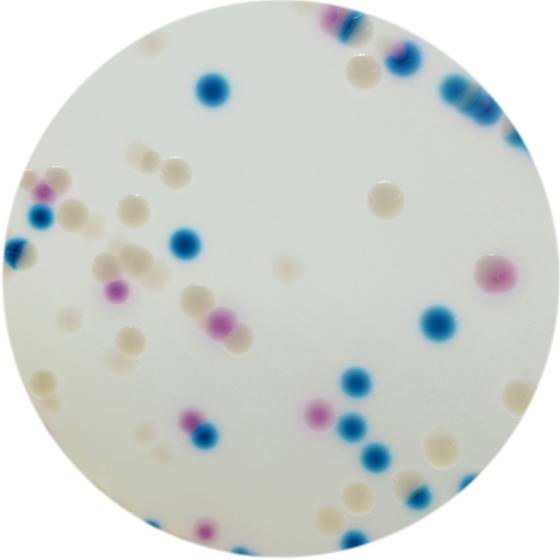

Über das Produkt
Chromogenes Medium zur Detektion von Colistin-resistenten Gram-negativen Bakterien.
Ähnliche Produkte
CHROMagar COL-APSE (5L)
CHROMagar mSuperCARBA Fertigplatten
CHROMagar™ COL-APSE Fertigplatten
Chromogenes Medium zur Detektion von Colistin-resistenten Gram-negativen Bakterien.
CHROMagar COL-APSE (5L)
CHROMagar mSuperCARBA Fertigplatten